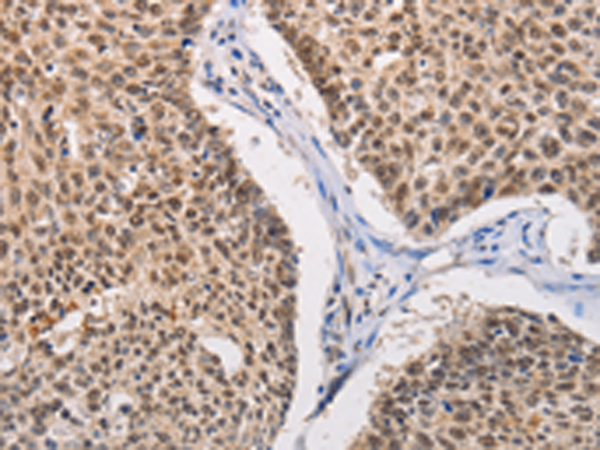
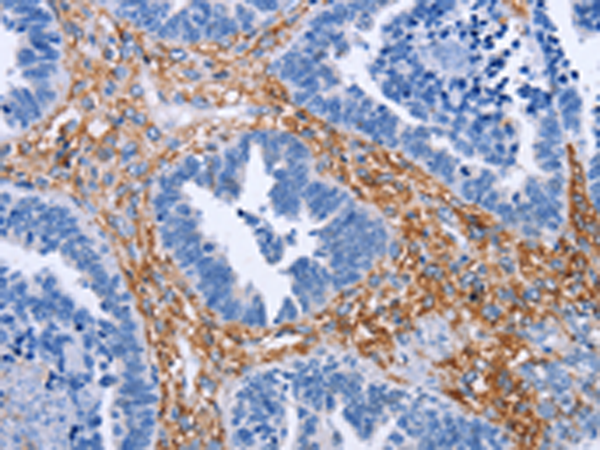
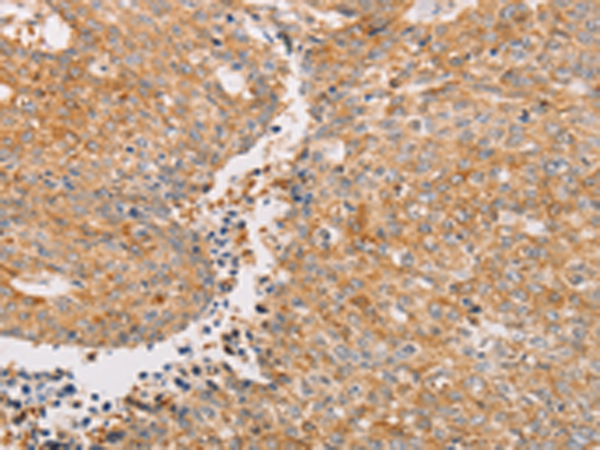
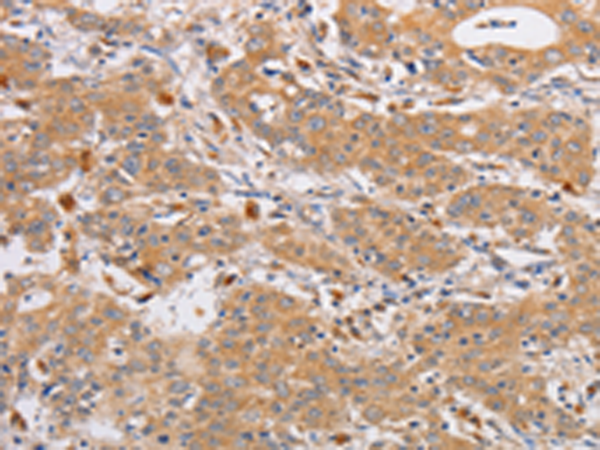

-
分类: 科研抗体货号: P07983别名: ADK2; AK 2应用: WB,IHC反应种属: Human, Mouse, Rat
-
分类: 科研抗体货号: P07967别名: LF; HLF2; GIG12; HEL110应用: WB,IHC反应种属: Human
-
分类: 科研抗体货号: P07976别名: MLCK; MLCK2; caMLCK应用: IHC反应种属: Human, Mouse, Rat
-
分类: 科研抗体货号: P07982别名: URK1应用: WB反应种属: Human, Mouse
-
分类: 科研抗体货号: P07975别名: PLK; STPK13应用: IHC反应种属: Human, Mouse, Rat
-
分类: 科研抗体货号: P07994别名: CDC5; CEF1; PCDC5RP; CDC5-LIKE; dJ319D22.1应用: IHC反应种属: Human, Mouse, Rat
-
分类: 科研抗体货号: P07981别名: SDPII应用: IHC反应种属: Human, Mouse, Rat
-
分类: 科研抗体货号: P07974别名:应用: IHC反应种属: Human, Mouse
-
分类: 科研抗体货号: P07993别名: LOX1; LOXIN; SLOX1; CLEC8A; SCARE1应用: WB,IHC反应种属: Human
-
分类: 科研抗体货号: P07979别名: CNK; FNK; PRK应用: IHC反应种属: Human, Mouse, Rat

鄂公网安备42018502007531号
鄂公网安备42018502007531号

